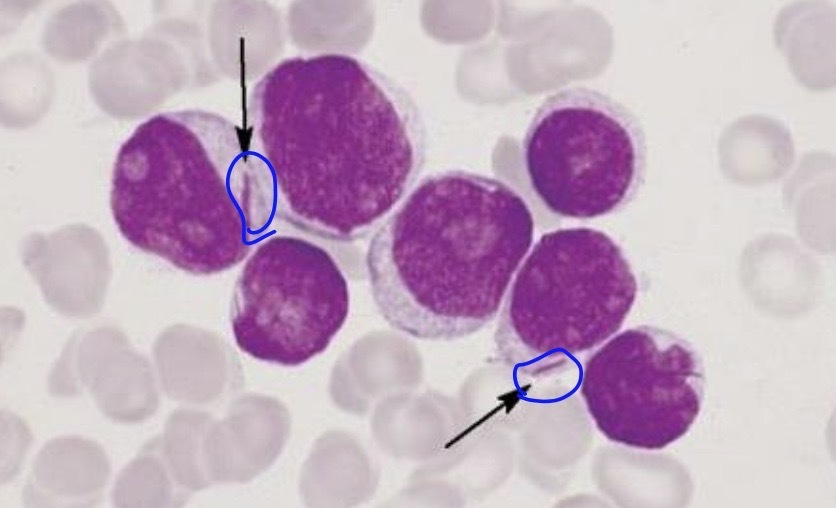
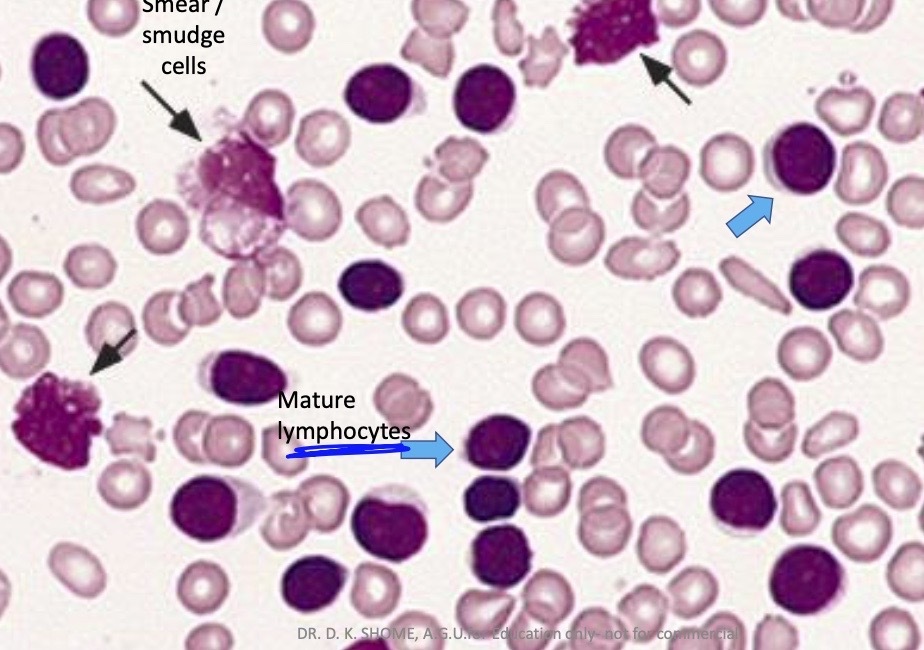
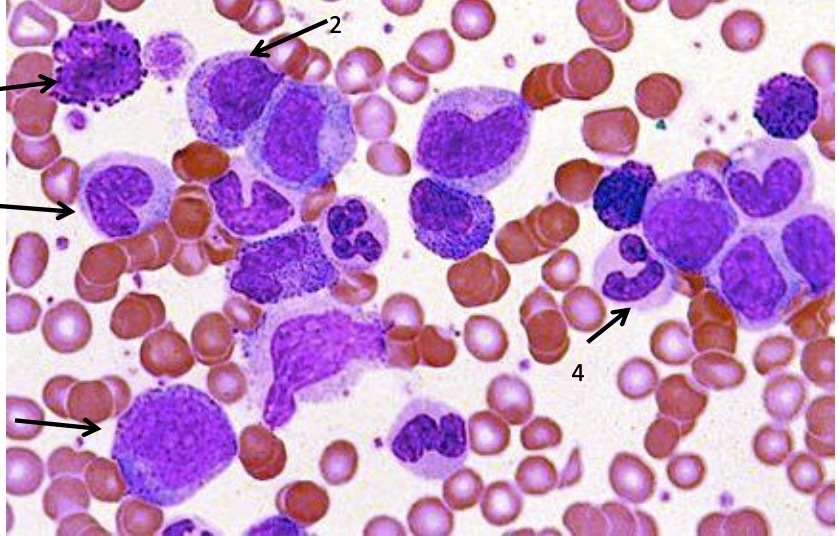

acute leukaemia presentation
-signs of BM failure
- bleeding
- fever
antigen marker commonly present on myeloid cells
CD33
in AML , what is indicated by black arrow
Auer rods
in AML ,what antigen markers are commonly detected
CD33 . CD13
good prognosis marker seen in AML
Translocation between 8 & 21 chromosomes in cytogenetic study
& t(15;17)
what is the diagnostic cytogenetic abnormality seen in acute premyelocytic leukaemia
t (15;17)
test to be done to confirm CML diagnosis
cytogenetic study
this karyotype is seen in which type of leukaemia

Chronic myeloid leukaemia
cytogenetic study in CML will reveal abnormality in which chromosomes
the Philadelphia chromosome
Between chromosomes 9 & 22
cella that are seen in blood smear that are Characteristic for CLL
smear / smudge cells
in flow cytometry of CLL , what antigen markers are commonly detected
CD19 , CD5 , CD23
levels of WBC in CLL
Increased
cells present in CML blood smear
Mature & immature granulocytes
minimum number of blast cells in blood/marrow required for a diagnosis of acute leukaemia ?
20%


